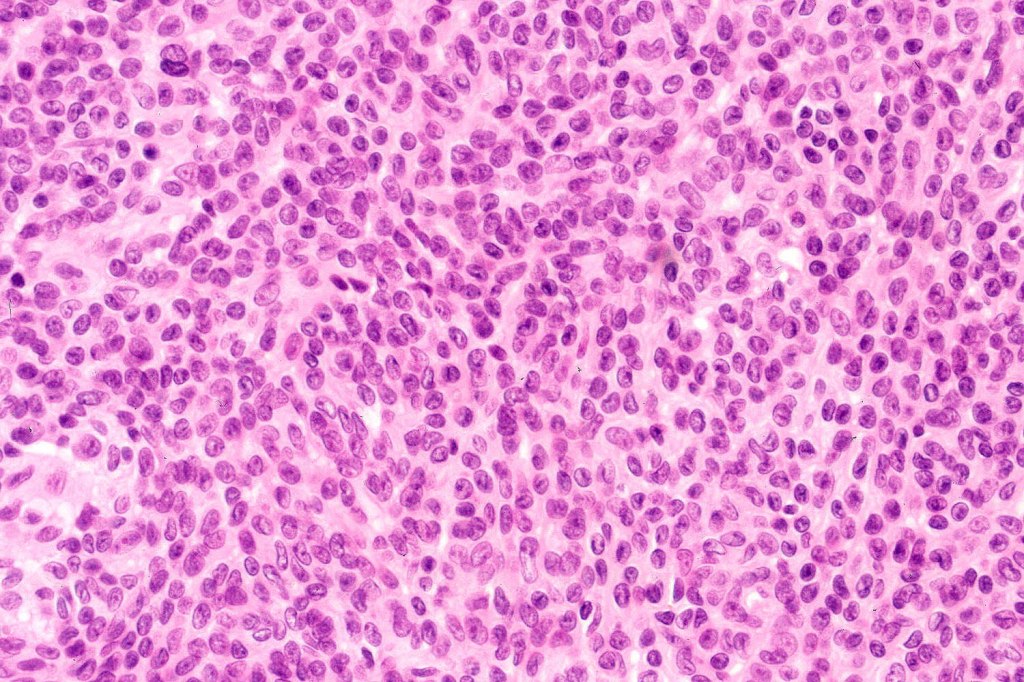
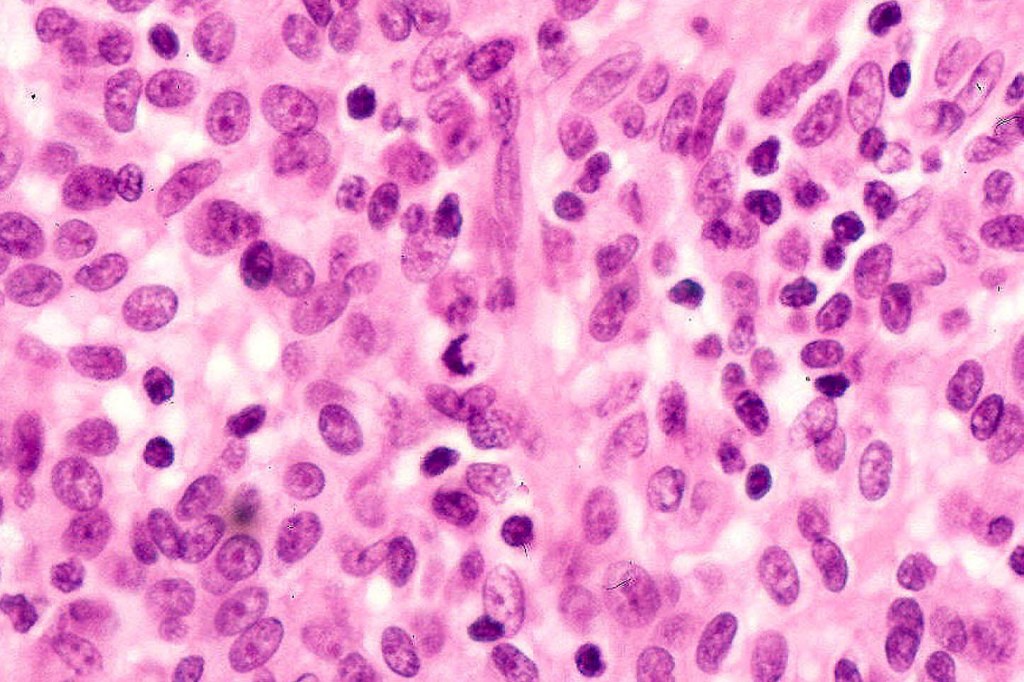
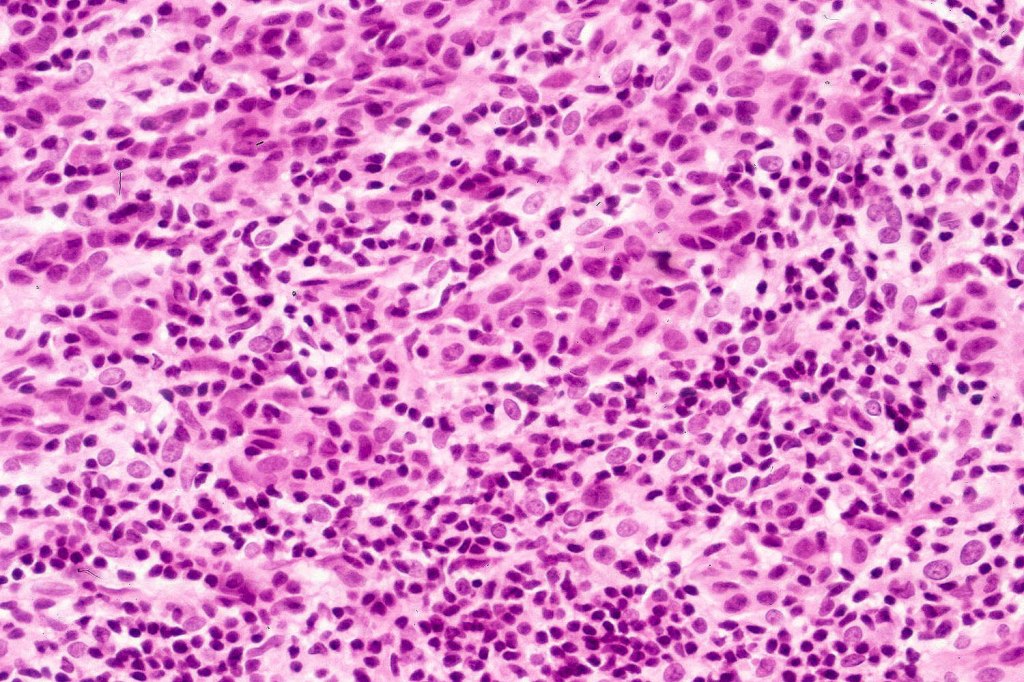
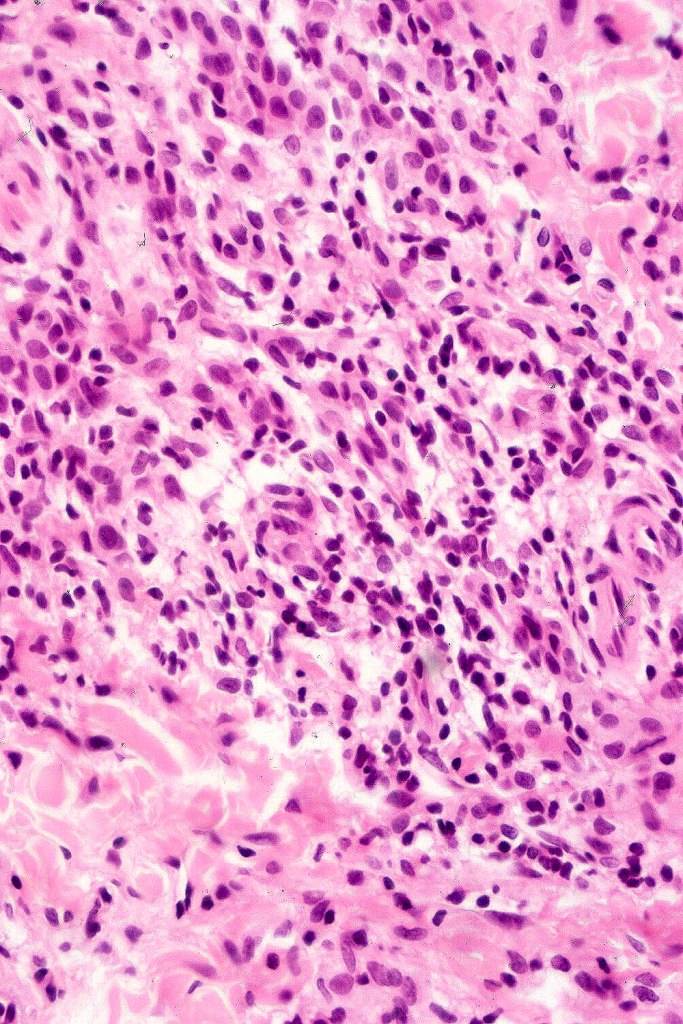
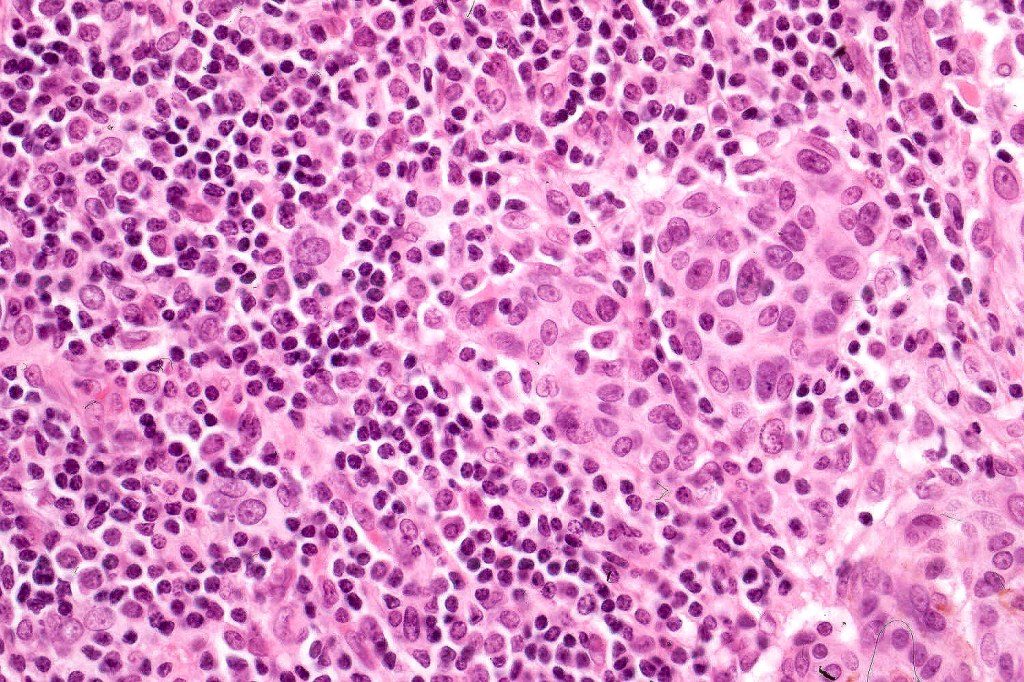
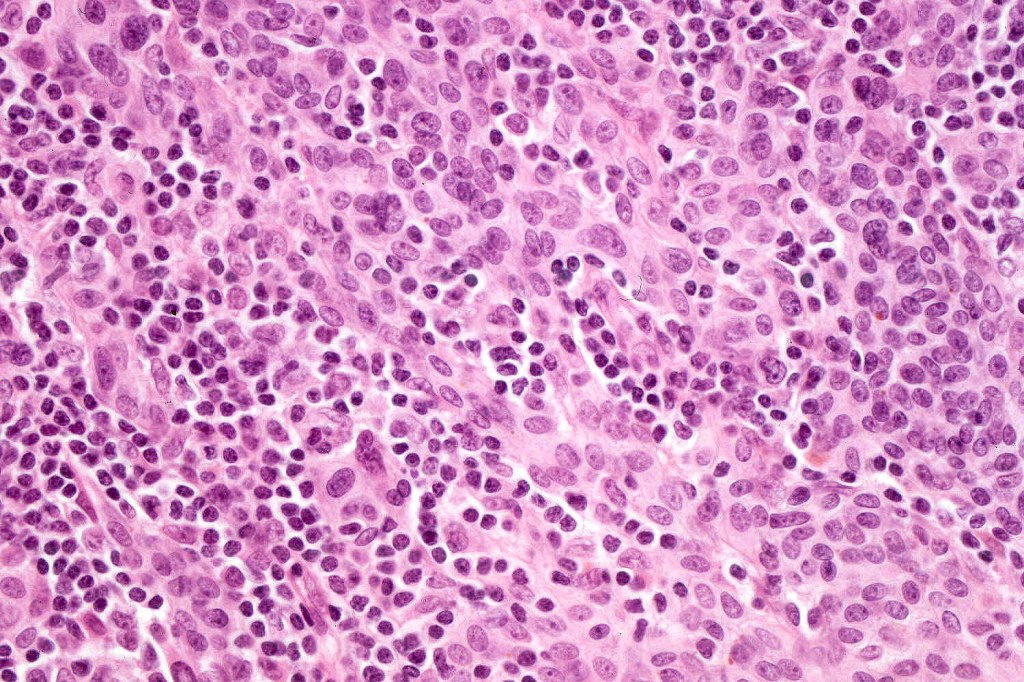

Halo nevus, also known as regressing nevus, Sutton’s nevus and leukoderma acquisitum centrifugum represents regression and in usually associated with a common/banal nevus. However it may also be seen with congenital nevus, dysplastic nevus, Spitz nevus, blue nevus and importantly with melanoma. A halo phenomenon may also be seen with a banal/common nevus in the absence of a halo (nevus with halo phenomenon). The latter is probably more common than true halo nevi.
Clinical features
•Presents as a pale/white border around a pre-existent nevus
•Occasionally multiple or even agminated
. Children & young adults (mean age 15 years) & are found in up to 1% of this population
•M=F
•Predilection for the back, less often the head & neck
. Can be associated with a prior episode of sunburn or importantly by the presence of melanoma somewhere else on the body
•Strong association with vitiligo & Turner syndrome
•Cases have been documented with treatment with immunotherapy


Histological features
•Hyperkeratosis, & acanthosis sometimes present, otherwise epidermis of normal thickness
•Usually compound nevus with intense infiltration by lymphocytes, histiocytes and occasional plasma cells, in particularly florrid examples immunohistchemistry may be necessary to identify the nevus cells
•CD8+ve>CD4+
•CD20 +ve to a much minor extent
. Sometimes prominent numbers of Langerhans cell
•Nevus cells often show degenerative atypia (nuclear pleomorphism, hyperchomatism & sometimes fine granular pigmentation (gray or gray/green)
•Melanophages present particularly in older lesions
•Mitoses can be seen in the lymphocytes but not the nevus cells
•The adjacent halo shows markedly diminished or no pigment and melanocytes may reduced in number

Leave a comment